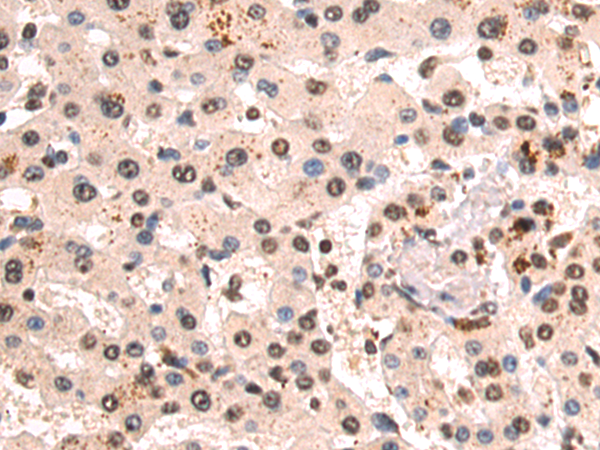

-
分类: 科研抗体货号: P03755别名: ARMD11应用: WB,IHC反应种属: Human
-
分类: 科研抗体货号: P03790别名: BOB1, OBF1, OCAB, OBF-1应用: IHC反应种属: Human, Mouse
-
分类: 科研抗体货号: P03739别名:应用: WB,IHC反应种属: Human, Mouse, Rat
-
分类: 科研抗体货号: P03751别名: ARFL2; MRCS1应用: WB,IHC反应种属: Human, Mouse, Rat
-
分类: 科研抗体货号: P03786别名: HST, KFGF, HST-1, HSTF1, K-FGF, HBGF-4应用: IHC反应种属: Human, Mouse
-
分类: 科研抗体货号: P03738别名: ARH6, ARHB, RHOH6应用: WB反应种属: Human, Mouse, Rat
-
分类: 科研抗体货号: P03819别名: K14, NFJ, CK14, EBS3, EBS4应用: WB,IHC反应种属: Human, Mouse, Rat
-
分类: 科研抗体货号: P03780别名: JFY1; PUMA; JFY-1应用: WB,IHC反应种属: Human
-
分类: 科研抗体货号: P03731别名: AMPK, HAMPKb应用: IHC反应种属: Human, Mouse, Rat
-
分类: 科研抗体货号: P03817别名: G5A; CK2B; CK2N; CSK2B应用: WB,IHC反应种属: Human, Mouse, Rat

鄂公网安备42018502007531号
鄂公网安备42018502007531号

